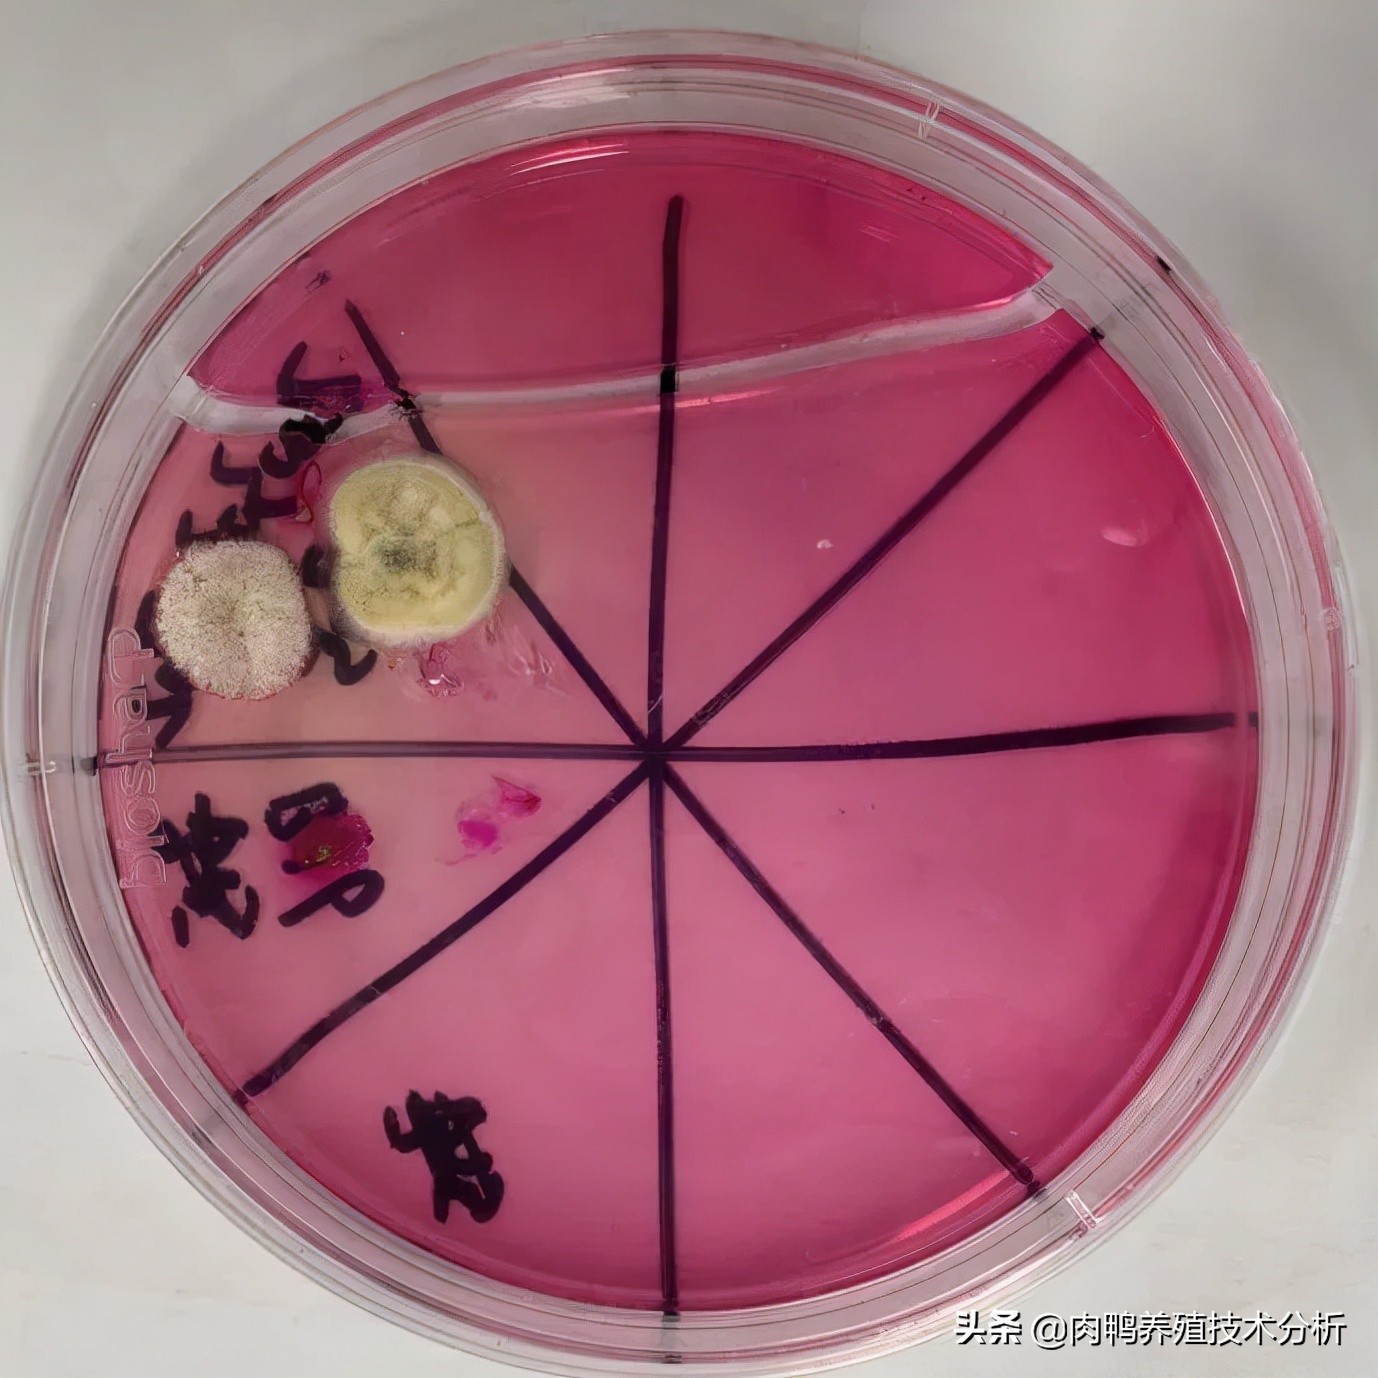
肉鸭曲霉菌中毒用什么脱霉剂,肉鸭霉菌预防用什么药

禽曲霉菌病
禽曲霉菌病,是多种禽类和哺乳动物的一种真菌性疾病,引起禽曲霉菌病的病原有烟曲霉,黄曲霉,黑曲霉,土曲霉,灰绿曲霉等,它们均有不同程度的致病性。曲霉菌以及它们所生产的孢子在自然界中分布广泛,禽类通过接触发霉的垫料,饲料,器具均会造成感染,而且曲霉菌会对家禽的呼吸道系统造成损伤,导致病情复杂化。
● 案例背景
2020年2月,山东一个体养鸭户赵某饲养的6000只樱桃谷肉鸭在12日龄突然发病,当日死亡一百多只,经检测为鸭病毒性肝炎,使用药物后情况有所好转,但还持续出现死亡,因此对其进行一系列的实验室检测与诊断。
● 临床症状
病鸭精神不振,羽毛松乱,两翅下垂,缩颈呆立,卧地不愿走动;两眼半闭,嗜睡,且呼吸困难,气喘,张口呼吸,并伴有腹泻;个别病鸭会出现头肿大,神经症状等。
● 剖检变化
剖检一部分病死鸭,主要病变在气囊、肺脏与气管,剖检可见肺脏与气囊表面散布着数目不等的米粒大小的黄白色结节(图1 ),且易与组织分离,肺脏出血,肺组织弹性消失,气管栓塞内有白色干酪物(图2);胆囊肿大,肝脏表面呈网格状(图3),脾脏坏死,出血,脾脏有大理石样病变(图4)。




图1-图4 剖检变病
● 霉菌分离培养
对剖检的病死鸭病料,从肺部无菌的进行细菌分离培养,并无菌采集病死鸭气囊处的白色结节,接种于孟加拉红琼脂培养基上,在恒温培养箱中,28℃培养24-72小时后进行观察,24h后观察发现有针尖大小的白色小点,48h后可以看到灰白色、绒毛状、圆形菌落,其为明显的霉菌菌落,图5。
图5 分离的霉菌菌落
●结论及讨论
结论 :
根据临床症状,剖检变化结合实验室检测,可以确定该鸭群感染了曲霉菌。
讨论 :
(1)近些年来,养鸭场不时发生肉鸭曲霉菌病,该病的发生往往与饲养管理有很大关系,特别是垫料与饲料的曲霉菌污染,认为雏鸭的饲料霉变是导致此次发生的原因,应加强饲料贮存和保管工作,不喂霉变饲料,养殖器具定期消毒,从而减少经济损失。
(2)如果鸭群已经发生霉菌感染,应更加注意饲料的情况,加强鸭场的环境消毒,特别是料槽与水线,应经常用消毒剂进行消毒;同时病鸭要及时隔离,并使用抗霉菌药物,霉易清,500克/袋兑水4000斤,连用4天。
(3)肉鸭曲霉菌病初期症状容易与一些呼吸道病相混淆,所以发病后应及时进行鉴别诊霉易清断,以免延误治疗,造成巨大的经济损失。